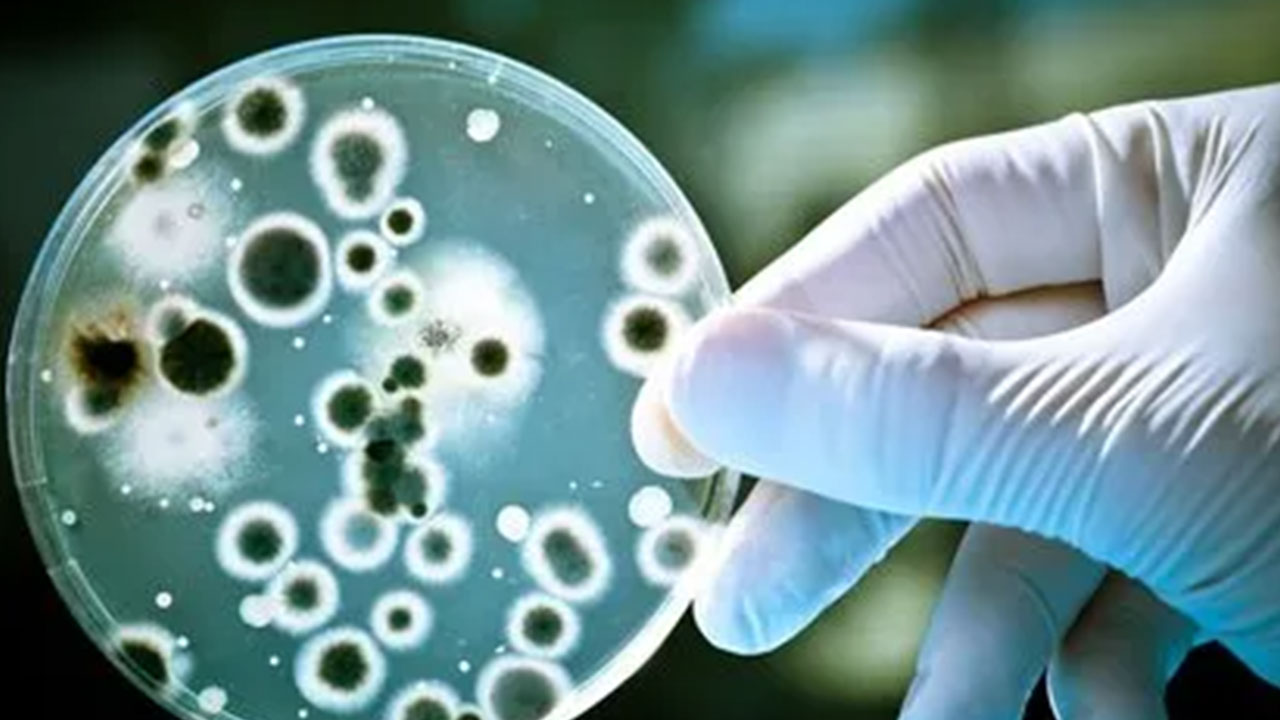
Foto - O sözde bilim insanlarına gece yarısı operasyonu! Kapı dışarı edildiler

O sözde bilim insanlarına gece yarısı operasyonu! Kapı dışarı edildiler
2020'nin başında patlak veren ve ulusal ekonomiler başta olmak üzere tüm dünya dengelerini altüst eden kovid tiyatrosunda son noktaya yaklaşılıyor.
2020'nin başında patlak veren ve ulusal ekonomiler başta olmak üzere tüm dünya dengelerini altüst eden kovid tiyatrosunda son noktaya yaklaşılıyor.
İnsanların yerlere devrilip öldüğü şeklindeki kurgusal görüntülerle tüm insanlığa korku salınan ve trilyonlarca dolarlık tıbbi operasyonlara yol açılan sürecin maskesi, Amerika'da Donald Trump'ın yeniden iktidara gelmesi ile düşmeye başladı.
Trump'ın Sağlık Bakanlığı'nı teslim ettiği aşı karşıtı Robert Kennedy'nin bir geceyarısı operasyonuyla Amerikan Ulusal Sağlık Enstitüsü'nün (NIH) mRNA sözde aşı çalışmaları dahil tüm Kovid projeleri durduruldu.
Pandemi isimli filmin yapımcılarından eski NIH Başkanı Anthony Fauci'nin eşi Christine Grady ve beş üst düzey yetkili ile çok sayıda laboratuvar başkanı ve yüzlerce personel Enstitü'den kapı dışarı edildi.
Ulusal Sağlık Enstitüsü'nden hibe alan onlarca proje ekibine de hibelerin durdurulduğuna ilişkin bilgilendirme mektupları gönderildi
Trump yönetiminin bu kararları almasında Kovid sürecindeki saçmalıkların, sözde pandemi kullanılarak ulusal bütçenin zarara uğratılmasının ve en önemlisi pandeminin bizzat varlığına olan derin inançsızlığın etkili olduğu belirtiliyor. Kovid pandemisine başından beri inanmayan Sağlık Bakanı Kennedy, birçok açıklamasında ilaç tröstlerini hedef almış ve mesela Pfizer firmasının mRNA aşılarının, aşı olmayanlara göre aşı olanlarda 5 misli daha fazla kalp krizine sebep olduğunu ortaya koymuştu.
WhatsApp İhbar Hattı
+90 (553) 313 94 23